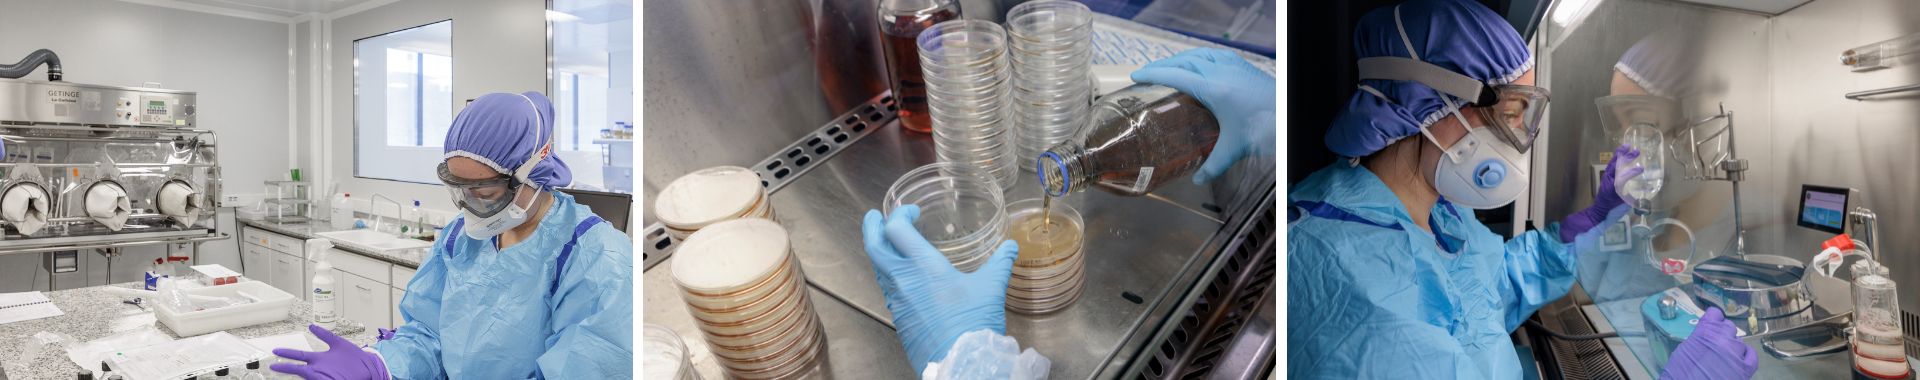
Analyses microbiologiques Eurofins BPT France

Recherche >>
Analyses microbiologiques
Contactez-nousLe réseau de laboratoires Eurofins BioPharma Product Testing France vous propose une large gamme de services microbiologiques pour les produits pharmaceutiques et les dispositifs médicaux pour le contrôle des produits finis, des produits intermédiaires et vracs, des matières premières et ingrédients, et de l'environnement de production.
Que cela soit en support de vos projets R&D ou au sujet du contrôle qualité de vos produits et procédés, nos équipes vous aident à garantir la conformité, l'efficacité et la sécurité de vos produits.
- Contrôle microbiologique des produits non stériles :
- Essais de dénombrement microbiens
- Recherche de microorganismes spécifiés
- Recherche ou dénombrement de Burkholderia Cepacia Complex
- Référentiels :
- Ph. Eur, chap. 2.6.12, 2.6.13 et 2.6.31 USP <61>, <62> et <60>
- ISO 11737-1
- Contrôle des produits stériles
- Tests de stérilité
- Recherche de Pyrogènes/endotoxines
- Contamination particulaire visible ou sub-visible
- Recherche de mycoplasmes
- Détection d’ADN résiduel
- Référentiels :
- Ph. Eur, chap. 2.6.1, 2.6.14, 2.6.7, 2.9.19, 2.9.20
- USP <85> USP <161>
- ISO 11737-2
- Efficacité de la conservation antimicrobienne
- Avec les souches de référence et/ou des souches sauvages
- Référentiels :
- Ph. Eur, chap. 5.1.3, USP<51>
- Titrage des antibiotiques
- Titrage chimique
- Titrage microbiologique
- Par diffusion
- Par turbidimétrie
- Monitoring environnemental
- Prélèvement et analyse des eaux purifiées et pour injection
- Prélèvement et analyse des gaz pharmaceutiques et air comprimé
- Contrôle des surfaces et de l’air
- Qualification des flux
- Qualification des salles propres
- Référentiels :
- Monographie PE, ISO 14644-x, EN 17141
- Identification & caractérisation des micro-organismes
- Identification protéomique
- Identification génotypique
- Séquençage comparatif unilocus (partiel, total)
- Séquençage comparatif multilocus
- Conservation sécurisée des produits biologiques
- Conservation des souches bactériennes et fongiques à -80 ou -130°C
- Conservation des lignées cellulaires, souches recombinantes, souches virales, plasmides, Master Cell Bank et Working Cell Bank
- Production à façon de souches calibrées (références ou sauvages)
- Master Cell Bank >10E8 UFC/mL
- Applicabilité des méthodes et fertilité des milieux : calibration <100 UFC/100 uL
- Evaluation de l’activité des désinfectants
- Validation de phase 1, phase 2 en suspension ou sur vos différents types de surface
- Référentiels :
- NF EN 1040, 1275, 1276, 1650, 16615, 13697, 22196, etc…
Pourquoi nous choisir ?
- Plus de 20 années d’expérience
- Analyses menées selon les référentiels en vigueur
- Flexibilité et réactivité de nos équipes pour répondre à vos besoins dans des délais impartis
Pour en savoir plus, regardez la rediffusion de notre webinaire : Validation des désinfectants : comment éviter les écarts réglementaires ?
Nous contacter
Si vous souhaitez travailler avec Eurofins sur un projet BioPharma, remplissez le formulaire de contact, nos équipes vous contacteront dans les meilleurs délais.
Merci pour votre demande